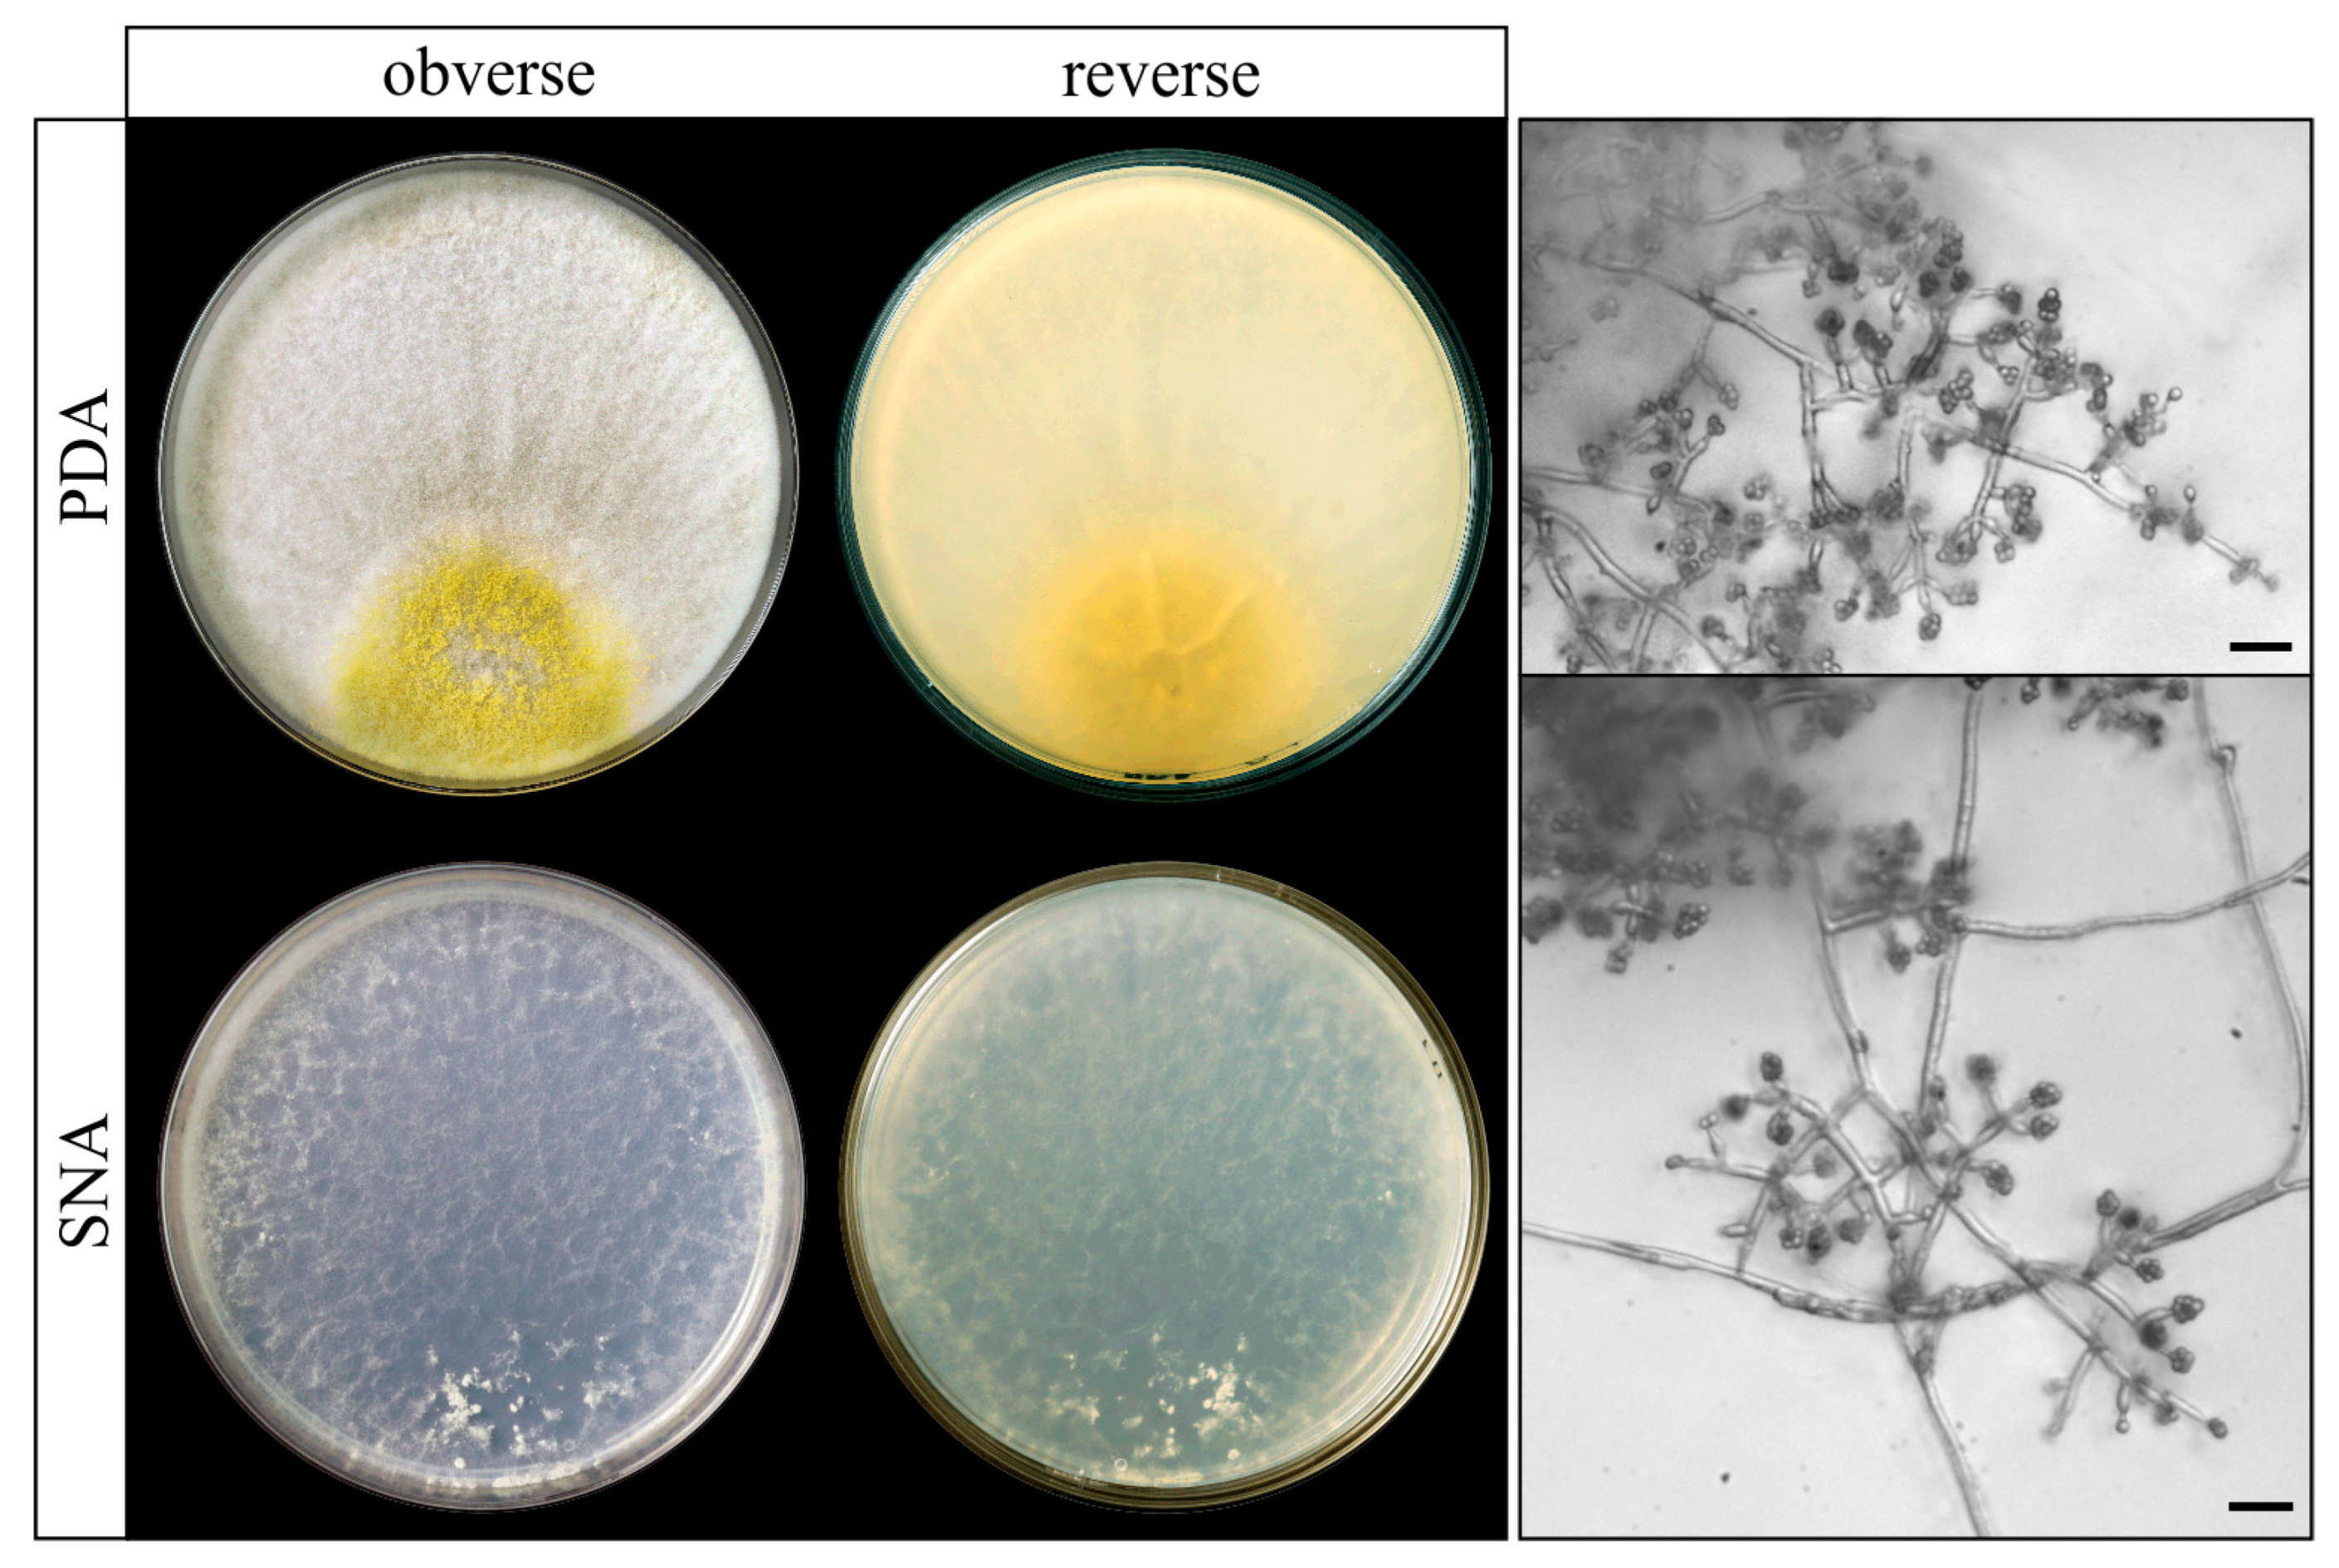
Agriculture 14 02016 g007 Agriculture 14 02016 g007

Biocontrol Potential of a Native Trichoderma Collection Against Fusarium oxysporum f. sp. cubense Subtropical Race 4
Abstract
1. Introduction
2. Materials and Methods
2.1. Isolates Used and Growth Conditions
2.2. Design of Oligonucleotides for PCR Amplification of Internal Fragments of Biocontrol Genes
2.3. PCR Amplifications and Screening of Biocontrol Genes
2.4. Kluyveromyces Marxianus CECT 1018 Assay
2.5. In Vitro Antifungal Assays Methodology
- Membrane antifungal assay. This procedure was used to quantify the ability of the Trichoderma isolates to produce in a solid medium metabolites and/or enzymes with inhibitory activity against Foc-STR4 strains. The antifungal assay was performed as previously described by Mayo et al. [32] with some modifications. Briefly, a sterile cellophane membrane was placed on the surface of the PDA medium, and Trichoderma plugs were incubated on this membrane for 48 h at 25 °C. After the removal of the membrane with the Trichoderma mycelia, Fusarium plugs were placed on the same plates to assess growth inhibition. In parallel, a Fusarium control was grown on PDA plates (without Trichoderma spp.) under the same conditions. The growth of the pathogen was monitored every day until the mycelium covered the entire surface of the Petri dish. Assays were performed in triplicate with each Fusarium strain. Photographs were taken after 7 days.
- Broth antifungal assay. This procedure was used to evaluate the ability of each Trichoderma isolate to produce in a liquid medium metabolites and enzymes with antifungal activity. PDA-sporulated plates were used to obtain a Trichoderma inoculum of 1 × 106 spores/mL of each isolate. Subsequently, the suspensions were inoculated in sterile 250 mL flaks containing 150 mL of Blakeeslee’s malt extract broth (MEBbl [33]) and incubated at 25 °C and 220 rpm in the dark for 24 h. Five milliliters of broth suspension (broth and mycelium) were filtered through a 0.22 µm pore sterile filter (Minisart, Sartorius Stedim, Misuri, USA, Biotech) and stored at −20 °C until use.
- 3.
- Direct confrontation antifungal assay. This assay was used to verify the ability of Trichoderma isolates to overgrow the pathogen. The process was performed as previously described by Mayo et al. [32] with some modifications. Each Trichoderma isolate was grown in a dual culture with Foc-STR4 strains 9 and 62. Both isolates (Trichoderma vs. Foc-STR4) were placed 5.5 cm apart on the same plate with PDA medium and incubated at 25 °C for 5 days. The behavior of Trichoderma against the pathogen was examined visually each day until Trichoderma had overgrown or surrounded the pathogen colony. Assays were performed in triplicate and single cultures of Fusarium were used as a control. Colony photographic documentation was conducted after 5 days. Likewise, in order to determine the mycoparasitism capacity (spirally coiled hyphae) of the different Trichoderma isolates, the mycelium was observed in the intersection areas of both colonies using an optical microscope Nikon Eclipse 80i with DIC (Tokyo, Japan).
2.6. Fungal DNA Extraction and Genome Sequencing
2.7. Phylogenetic Analysis
2.8. Statistical Analysis
3. Results
3.1. Screening of Biocontrol Genes in the Collection of Trichoderma Isolates
3.2. In Vitro Antifungal Assays
3.2.1. Membrane Antifungal Assay
3.2.2. Broth Antifungal Assay
3.2.3. Direct Confrontation Antifungal Assay
3.3. Analysis of the T. atrobrunneum TF03 Genome Sequence
3.4. Phylogenetic Analyses
4. Discussion
5. Conclusions
Supplementary Materials
Author Contributions
Funding
Institutional Review Board Statement
Data Availability Statement
Acknowledgments
Conflicts of Interest
References
- Food and Agriculture Organization of the United Nations (FAO). FAOSTAT Database. Available online: https://www.fao.org/faostat/en/#home (accessed on 3 January 2024).
- Ordonez, N.; Seidl, M.F.; Waalwijk, C.; Drenth, A.; Kilian, A.; Thomma, B.P.H.J.; Ploetz, R.C.; Kema, G.H.J. Worse Comes to Worst: Bananas and Panama Disease—When Plant and Pathogen Clones Meet. PLoS Pathog. 2015, 11, e1005197. [Google Scholar] [CrossRef] [PubMed]
- Instituto Canario de Estadística. ISTAC. Available online: https://www.gobiernodecanarias.org/istac/ (accessed on 22 March 2024).
- Food and Agriculture Organization of the United Nations (FAO). Market Review Preliminary Results 2023. Major Trop. Fruits 2023, 15, 4. [Google Scholar]
- Ploetz, R.C. Management of Fusarium Wilt of Banana: A Review with Special Reference to Tropical Race 4. Crop Prot. 2015, 73, 7–15. [Google Scholar] [CrossRef]
- Waite, B.H.; Stover, R.H. Studies on Fusarium Wilt of Bananas: VI. variability and the cultivar concept in Fusarium oxysporum f. cubense. Can. J. Bot. 1960, 38, 985–994. [Google Scholar] [CrossRef]
- Su, H.; Hwang, S.; Ko, W. Fusarial Wilt of Cavendish Bananas in Taiwan. Plant Dis. 1986, 70, 814. [Google Scholar]
- Ploetz, R.C. Fusarium Wilt of Banana. Phytopathology 2015, 105, 1512–1521. [Google Scholar] [CrossRef]
- Perera González, S.; Brito López, P.; Hernández, D.; Laich, F.; de Rosa, S.F. Study on Panama Disease Caused Fusarium oxysporum f. sp. cubense in Banana Crops of Tenerife; GMR Canarias: Canary Islands, Spain, 2023. [Google Scholar]
- Bubici, G.; Kaushal, M.; Prigigallo, M.I.; Cabanás, C.G.L.; Mercado-Blanco, J. Biological Control Agents against Fusarium Wilt of Banana. Front. Microbiol. 2019, 10, 616. [Google Scholar] [CrossRef]
- Butler, B.Y.D. Florida Forecasts. Nature 2013, 504, 195–196. [Google Scholar] [CrossRef]
- Guo, G.; Wang, B.; Ma, W.; Li, X.; Yang, X.; Zhu, C.; Ming, J.; Zeng, H. Biocontrol of Fusarium Wilt of Banana: Key Influence Factors and Strategies. Afr. J. Microbiol. Res. 2013, 7, 4835–4843. [Google Scholar] [CrossRef]
- Benítez, T.; Rincón, A.M.; Limón, M.C.; Codón, A.C. Biocontrol Mechanisms of Trichoderma Strains. Int. Microbiol. 2004, 7, 249–260. [Google Scholar]
- Woo, S.L.; Hermosa, R.; Lorito, M.; Monte, E. Trichoderma: A Multipurpose, Plant-Beneficial Microorganism for Eco-Sustainable Agriculture. Nat. Rev. Microbiol. 2023, 21, 312–326. [Google Scholar] [CrossRef] [PubMed]
- Reithner, B.; Brunner, K.; Schuhmacher, R.; Peissl, I.; Seidl, V.; Krska, R.; Zeilinger, S. The G Protein α Subunit Tga1 of Trichoderma Atroviride Is Involved in Chitinase Formation and Differential Production of Antifungal Metabolites. Fungal Genet. Biol. 2005, 42, 749–760. [Google Scholar] [CrossRef] [PubMed]
- Mukherjee, P.K.; Mendoza-Mendoza, A.; Zeilinger, S.; Horwitz, B.A. Mycoparasitism as a Mechanism of Trichoderma-Mediated Suppression of Plant Diseases. Fungal Biol. Rev. 2022, 39, 15–33. [Google Scholar] [CrossRef]
- Cai, F.; Druzhinina, I.S. In Honor of John Bissett: Authoritative Guidelines on Molecular Identification of Trichoderma; Springer: Cham, Switzerland, 2021; Volume 107. [Google Scholar] [CrossRef]
- Harman, G.E.; Howell, C.R.; Viterbo, A.; Chet, I.; Lorito, M. Trichoderma Species-Opportunistic, Avirulent Plant Symbionts. Nat. Rev. Microbiol. 2004, 2, 43–56. [Google Scholar] [CrossRef]
- Pozo, M.J.; Baek, J.M.; García, J.M.; Kenerley, C.M. Functional Analysis of Tvsp1, a Serine Protease-Encoding Gene in the Biocontrol Agent Trichoderma virens. Fungal Genet. Biol. 2004, 41, 336–348. [Google Scholar] [CrossRef]
- Geremia, R.A.; Goldman, G.H.; Jacobs, D.; Ardrtes, W.; Vila, S.B.; Van Montagu, M.; Herrera-Estrella, A. Molecular Characterization of the Proteinase-encoding Gene, Prb1, Related to Mycoparasitism by Trichoderma harzianum. Mol. Microbiol. 1993, 8, 603–613. [Google Scholar] [CrossRef]
- Izzati, N.A.M.Z.; Maryam, S.S.S.A.R.; Azwady, N.A.A. Suppression of Fusarium Wilt of Banana with an Application of Trichoderma asperellum Inoculants. IOP Conf. Ser. Earth Environ. Sci. 2019, 260, 012119. [Google Scholar] [CrossRef]
- Damodaran, T.; Rajan, S.; Muthukumar, M.; Gopal, R.; Yadav, K.; Kumar, S.; Ahmad, I.; Kumari, N.; Mishra, V.K.; Jha, S.K. Biological Management of Banana Fusarium Wilt Caused by Fusarium oxysporum f. sp. cubense Tropical Race 4 Using Antagonistic Fungal Isolate CSR-T-3 (Trichoderma reesei). Front. Microbiol. 2020, 11, 595845. [Google Scholar] [CrossRef]
- Damodaran, T.; Mishra, M.; Muthukumar, M.; Rajan, S.; Yadav, K.; Kumar, A.; Debnath, P.; Kumari, S.; Bora, P.; Gopal, R.; et al. Secondary Metabolite Induced Tolerance to Fusarium oxysporum f. sp. cubense TR4 in Banana Cv. Grand Naine through in Vitro Bio-Immunization: A Prospective Research Translation from Induction to Field Tolerance. Front. Microbiol. 2023, 14, 1233469. [Google Scholar] [CrossRef]
- Thangavelu, R.; Gopi, M. Combined Application of Native Trichoderma Isolates Possessing Multiple Functions for the Control of Fusarium Wilt Disease in Banana Cv. Grand Naine. Biocontrol Sci. Technol. 2015, 25, 1147–1164. [Google Scholar] [CrossRef]
- Thangavelu, R.; Palaniswami, A.; Velazhahan, R. Mass Production of Trichoderma harzianum for Managing Fusarium Wilt of Banana. Agric. Ecosyst. Environ. 2004, 103, 259–263. [Google Scholar] [CrossRef]
- Galarza, L.; Akagi, Y.; Takao, K.; Kim, C.S.; Maekawa, N.; Itai, A.; Peralta, E.; Santos, E.; Kodama, M. Characterization of Trichoderma Species Isolated in Ecuador and Their Antagonistic Activities against Phytopathogenic Fungi from Ecuador and Japan. J. Gen. Plant Pathol. 2015, 81, 201–210. [Google Scholar] [CrossRef]
- Taribuka, J.; Wibowo, A.; M Widyastuti, S.; Sumardiyono, C. Potency of Six Isolates of Biocontrol Agents Endophytic Trichoderma against Fusarium Wilt on Banana. J. Degrad. Min. Lands Manag. 2017, 4, 723–731. [Google Scholar] [CrossRef]
- Long, W.; Chen, Y.; Wei, Y.; Feng, J.; Zhou, D.; Cai, B.; Qi, D.; Zhang, M.; Zhao, Y.; Li, K.; et al. A Newly Isolated Trichoderma parareesei N4-3 Exhibiting a Biocontrol Potential for Banana Fusarium Wilt by Hyperparasitism. Front. Plant Sci. 2023, 14, 1289959. [Google Scholar] [CrossRef] [PubMed]
- Correa-Delgado, R.; Brito-López, P.; Jaizme Vega, M.C.; Laich, F. Biodiversity of Trichoderma Species of Healthy and Fusarium Wilt-Infected Banana Rhizosphere Soils in Tenerife (Canary Islands, Spain). Front. Microbiol. 2024, 15, 1376602. [Google Scholar] [CrossRef]
- Maryani, N.; Lombard, L.; Poerba, Y.S.; Subandiyah, S.; Crous, P.W.; Kema, G.H.J. Phylogeny and Genetic Diversity of the Banana Fusarium Wilt Pathogen Fusarium oxysporum f. sp. cubense in the Indonesian Centre of Origin. Stud. Mycol. 2019, 92, 155–194. [Google Scholar] [CrossRef]
- Cardoza, R.E.; Malmierca, M.G.; Hermosa, M.R.; Alexander, N.J.; McCormick, S.P.; Proctor, R.H.; Tijerino, A.M.; Rumbero, A.; Monte, E.; Gutiérrez, S. Identification of Loci and Functional Characterization of Trichothecene Biosynthesis Genes in Filamentous Fungi of the Genus Trichoderma. Appl. Environ. Microbiol. 2011, 77, 4867–4877. [Google Scholar] [CrossRef]
- Mayo, S.; Gutiérrez, S.; Malmierca, M.G.; Lorenzana, A.; Campelo, M.P.; Hermosa, R.; Casquero, P.A. Influence of Rhizoctonia solani and Trichoderma spp. in Growth of Bean (Phaseolus Vulgaris L.) and in the Induction of Plant Defense-Related Genes. Front. Plant Sci. 2015, 6, 00685. [Google Scholar] [CrossRef]
- Blakeslee, A. Lindner’s Roll Tube Method of Separation Cultures. Phytopathology 1915, 5, 68–69. [Google Scholar]
- Bankevich, A.; Nurk, S.; Antipov, D.; Gurevich, A.A.; Dvorkin, M.; Kulikov, A.S.; Lesin, V.M.; Nikolenko, S.I.; Pham, S.; Prjibelski, A.D.; et al. SPAdes: A New Genome Assembly Algorithm and Its Applications to Single-Cell Sequencing. J. Comput. Biol. 2012, 19, 455–477. [Google Scholar] [CrossRef]
- Stanke, M.; Keller, O.; Gunduz, I.; Hayes, A.; Waack, S.; Morgenstern, B. AUGUSTUS: Ab Initio Prediction of Alternative Transcripts. Nucleic Acids Res. 2006, 34, 435–439. [Google Scholar] [CrossRef] [PubMed]
- Hoff, K.J.; Stanke, M. WebAUGUSTUS—A Web Service for Training AUGUSTUS and Predicting Genes in Eukaryotes. Nucleic Acids Res. 2013, 41, 123–128. [Google Scholar] [CrossRef] [PubMed]
- Conesa, A.; Götz, S.; García-Gómez, J.M.; Terol, J.; Talón, M.; Robles, M. Blast2GO: A Universal Tool for Annotation, Visualization and Analysis in Functional Genomics Research. Bioinformatics 2005, 21, 3674–3676. [Google Scholar] [CrossRef] [PubMed]
- Medema, M.H.; Blin, K.; Cimermancic, P.; De Jager, V.; Zakrzewski, P.; Fischbach, M.A.; Weber, T.; Takano, E.; Breitling, R. AntiSMASH: Rapid Identification, Annotation and Analysis of Secondary Metabolite Biosynthesis Gene Clusters in Bacterial and Fungal Genome Sequences. Nucleic Acids Res. 2011, 39, 339–346. [Google Scholar] [CrossRef]
- Gutiérrez, S.; McCormick, S.P.; Cardoza, R.E.; Kim, H.S.; Yugueros, L.L.; Vaughan, M.M.; Carro-Huerga, G.; Busman, M.; Sáenz de Miera, L.E.; Jaklitsch, W.M.; et al. Distribution, Function, and Evolution of a Gene Essential for Trichothecene Toxin Biosynthesis in Trichoderma. Front. Microbiol. 2021, 12, 791641. [Google Scholar] [CrossRef]
- Kumar, S.; Shukla, V.; Dubey, M.K.; Upadhyay, R.S. Activation of Defense Response in Common Bean against Stem Rot Disease Triggered by Trichoderma erinaceum and Trichoderma viride. J. Basic Microbiol. 2021, 61, 910–922. [Google Scholar] [CrossRef]
- Vaidya, G.; Lohman, D.; Rudolf, M. SequenceMatrix: Concatenation Software for the Fast Assembly of Multi-gene Datasets with Character Set and Codon Information. Cladistics 2011, 27, 171–180. [Google Scholar] [CrossRef]
- Nguyen, L.T.; Schmidt, H.A.; Von Haeseler, A.; Minh, B.Q. IQ-TREE: A Fast and Effective Stochastic Algorithm for Estimating Maximum-Likelihood Phylogenies. Mol. Biol. Evol. 2015, 32, 268–274. [Google Scholar] [CrossRef]
- Minh, B.Q.; Hahn, M.W.; Lanfear, R. New Methods to Calculate Concordance Factors for Phylogenomic Datasets. Mol. Biol. Evol. 2020, 37, 2727–2733. [Google Scholar] [CrossRef]
- Jaklitsch, W.M.; Voglmayr, H. Biodiversity of Trichoderma (Hypocreaceae) in Southern Europe and Macaronesia. Stud. Mycol. 2015, 80, 1–87. [Google Scholar] [CrossRef]
- Malmierca, M.G.; Cardoza, R.E.; Alexander, N.J.; McCormick, S.P.; Collado, I.G.; Hermosa, R.; Monte, E.; Gutiérrez, S. Relevance of Trichothecenes in Fungal Physiology: Disruption of Tri5 in Trichoderma arundinaceum. Fungal Genet. Biol. 2013, 53, 22–33. [Google Scholar] [CrossRef] [PubMed]
- Kubicek, C.P.; Steindorff, A.S.; Chenthamara, K.; Manganiello, G.; Henrissat, B.; Zhang, J.; Cai, F.; Kopchinskiy, A.G.; Kubicek, E.M.; Kuo, A.; et al. Evolution and Comparative Genomics of the Most Common Trichoderma Species. BMC Genom. 2019, 20, 485. [Google Scholar] [CrossRef] [PubMed]
- Papavizas, G.C. Trichoderma and Gliocladium: Biology, Ecology, and Potential for Biocontrol. Annu. Rev. Phytopathol. 1985, 23, 23–54. [Google Scholar] [CrossRef]
- Gams, W.; Bissett, J. Secondary Metabolism in Trichoderma and Gliocladium. In Trichoderma and Gliocladium; CRC Press: London, UK, 1998; Volume 1, pp. 153–206. [Google Scholar]
- Marra, R.; Gutiérrez, S.; Woo, S.L.; Bonanomi, G.; Vinale, F. Editorial: Designing Bio-Formulations Based on Organic Amendments, Beneficial Microbes and Their Metabolites. Front. Microbiol. 2022, 12, 832149. [Google Scholar] [CrossRef]
- Poveda, J. Trichoderma as Biocontrol Agent against Pests: New Uses for a Mycoparasite. Biol. Control 2021, 159, 104634. [Google Scholar] [CrossRef]
- Woo, S.L.; Ruocco, M.; Vinale, F.; Nigro, M.; Marra, R.; Lombardi, N.; Pascale, A.; Lanzuise, S.; Manganiello, G.; Lorito, M. Trichoderma-Based Products and Their Widespread Use in Agriculture. Open Mycol. J. 2014, 8, 71–126. [Google Scholar] [CrossRef]
- Álvarez-García, S.; Mayo-Prieto, S.; Gutiérrez, S.; Casquero, P.A. Self-Inhibitory Activity of Trichoderma Soluble Metabolites and Their Antifungal Effects on Fusarium oxysporum. J. Fungi 2020, 6, 176. [Google Scholar] [CrossRef]
- Ruano-Rosa, D.; del Moral-Navarrete, L.; Lopez-Herrera, C.J. Selección de Aislados de Trichoderma spp. Antagonistas a Rosellinia necatrix. Span. J. Agric. Res. 2010, 8, 1084–1097. [Google Scholar] [CrossRef]
- Cardoza, R.E.; Mayo-Prieto, S.; Martínez-Reyes, N.; McCormick, S.P.; Carro-Huerga, G.; Campelo, M.P.; Rodríguez-González, Á.; Lorenzana, A.; Proctor, R.H.; Casquero, P.A.; et al. Effects of Trichothecene Production by Trichoderma arundinaceum Isolates from Bean-Field Soils on the Defense Response, Growth and Development of Bean Plants (Phaseolus Vulgaris). Front. Plant Sci. 2022, 13, 1005906. [Google Scholar] [CrossRef]
- Mayo-Prieto, S.; Campelo, M.P.; Lorenzana, A.; Rodríguez-González, A.; Reinoso, B.; Gutiérrez, S.; Casquero, P.A. Antifungal Activity and Bean Growth Promotion of Trichoderma Strains Isolated from Seed vs Soil. Eur. J. Plant Pathol. 2020, 158, 817–828. [Google Scholar] [CrossRef]
- Cardoza, R.E.; McCormick, S.P.; Izquierdo-Bueno, I.; Martínez-Reyes, N.; Lindo, L.; Brown, D.W.; Collado, I.G.; Proctor, R.H.; Gutiérrez, S. Identification of Polyketide Synthase Genes Required for Aspinolide Biosynthesis in Trichoderma arundinaceum. Appl. Microbiol. Biotechnol. 2022, 106, 7153–7171. [Google Scholar] [CrossRef] [PubMed]
- Carro-Huerga, G.; Mayo-Prieto, S.; Rodríguez-González, Á.; Cardoza, R.E.; Gutiérrez, S.; Casquero, P.A. Vineyard Management and Physicochemical Parameters of Soil Affect Native Trichoderma Populations, Sources of Biocontrol Agents against Phaeoacremonium minimum. Plants 2023, 12, 887. [Google Scholar] [CrossRef] [PubMed]
- Carrero-Carrón, I.; Trapero-Casas, J.L.; Olivares-García, C.; Monte, E.; Hermosa, R.; Jiménez-Díaz, R.M. Trichoderma asperellum Is Effective for Biocontrol of Verticillium Wilt in Olive Caused by the Defoliating Pathotype of Verticillium dahliae. Crop Prot. 2016, 88, 45–52. [Google Scholar] [CrossRef]
- Porteous-Álvarez, A.J.; Fernández-Marcos, A.; Ramírez-Lozano, D.; Mayo-Prieto, S.; Cardoza, R.E.; Gutiérrez, S.; Casquero, P.A. Native Trichoderma Isolates from Soil and Rootstock to Fusarium spp. Control and Growth Promotion of Humulus lupulus L. Plantlets. Agriculture 2023, 13, 720. [Google Scholar] [CrossRef]
- Lindo, L.; McCormick, S.P.; Cardoza, R.E.; Brown, D.W.; Kim, H.S.; Alexander, N.J.; Proctor, R.H.; Gutiérrez, S. Effect of Deletion of a Trichothecene Toxin Regulatory Gene on the Secondary Metabolism Transcriptome of the Saprotrophic Fungus Trichoderma arundinaceum. Fungal Genet. Biol. 2018, 119, 29–46. [Google Scholar] [CrossRef]
- Taghdi, Y.; Hermosa, R.; Sara, D.; Rubio, M.B.; Essalmani, H.; Nicolás, C.; Monte, E. Effectiveness of Composts and Trichoderma Strains for Control of Fusarium Wilt of Tomato. Phytopathol. Mediterr. 2015, 54, 241–252. [Google Scholar] [CrossRef]
- Anand, S.; Jayarama, R. Biocontrol Potential of Trichoderma sp. against Plant Pathogens. Int. J. Agric. Sci. 2009, 1, 30–39. [Google Scholar] [CrossRef][Green Version]
- Ivonne González, D.I.; Martínez, B.; Arias, Y.; González, N.; Miranda, I.; Peteira, B. Induction of Chitinases and Glucanases in Trichoderma spp. Biotecnol. Apl. 2012, 29, 12–16. [Google Scholar]
- Kobori, N.N.; Mascarin, G.M.; Jackson, M.A.; Schisler, D.A. Liquid Culture Production of Microsclerotia and Submerged Conidia by Trichoderma harzianum Active against Damping-off Disease Caused by Rhizoctonia solani. Fungal Biol. 2015, 119, 179–190. [Google Scholar] [CrossRef]
- Nielsen, K.F.; Gräfenhan, T.; Zafari, D.; Thrane, U. Trichothecene Production by Trichoderma brevicompactum. J. Agric. Food Chem. 2005, 53, 8190–8196. [Google Scholar] [CrossRef]
- Zhang, S.; Xu, B.; Zhang, J.; Gan, Y. Identification of the Antifungal Activity of Trichoderma longibrachiatum T6 and Assessment of Bioactive Substances in Controlling Phytopathgens. Pestic. Biochem. Physiol. 2018, 147, 59–66. [Google Scholar] [CrossRef] [PubMed]
- Olowe, O.M.; Nicola, L.; Asemoloye, M.D.; Akanmu, A.O.; Sobowale, A.A.; Babalola, O.O. Characterization and Antagonistic Potentials of Selected Rhizosphere Trichoderma Species against Some Fusarium Species. Front. Microbiol. 2022, 13, 985874. [Google Scholar] [CrossRef] [PubMed]
- Verma, M.; Brar, S.K.; Tyagi, R.D.; Surampalli, R.Y.; Valéro, J.R. Antagonistic Fungi, Trichoderma spp.: Panoply of Biological Control. Biochem. Eng. J. 2007, 37, 1–20. [Google Scholar] [CrossRef]
- Howell, C.R. Mechanisms Employed by Trichoderma Species in the Biological Control of Plant Diseases: The History and Evolution of Current Concepts. Plant Dis. 2003, 87, 4–10. [Google Scholar] [CrossRef] [PubMed]
- Thangavelu, R.; Mustaffa, M. A Potential Isolate of Trichoderma viride NRCB1 and Its Mass Production for the Effective Management of Fusarium Wilt Disease in Banana. Tree For. Sci. Biotechnol. 2010, 4, 76–84. [Google Scholar]
- Natsiopoulos, D.; Tziolias, A.; Lagogiannis, I.; Mantzoukas, S.; Eliopoulos, P.A. Growth-Promoting and Protective Effect of Trichoderma atrobrunneum and T. Simmonsii on Tomato against Soil-Borne Fungal Pathogens. Crops 2022, 2, 202–217. [Google Scholar] [CrossRef]
- Pavlovskaya, N.; Gneusheva, I.; Solokhina, I.; Ageeva, N. The Biological Activity of Subspecies Trichoderma harzianum against Fusarium oxysporum, the Causative Agent of Fusarium Wilt Cucumber in Vitro. BIO Web Conf. 2020, 21, 00021. [Google Scholar] [CrossRef]
- Zhang, J.; Bayram Akcapinar, G.; Atanasova, L.; Rahimi, M.J.; Przylucka, A.; Yang, D.; Kubicek, C.P.; Zhang, R.; Shen, Q.; Druzhinina, I.S. The Neutral Metallopeptidase NMP1 of Trichoderma guizhouense Is Required for Mycotrophy and Self-Defence. Environ. Microbiol. 2016, 18, 580–597. [Google Scholar] [CrossRef]
- Pang, G.; Sun, T.; Yu, Z.; Yuan, T.; Liu, W.; Zhu, H.; Gao, Q.; Yang, D.; Kubicek, C.P.; Zhang, J.; et al. Azaphilones Biosynthesis Complements the Defence Mechanism of Trichoderma guizhouense against Oxidative Stress. Environ. Microbiol. 2020, 22, 4808–4824. [Google Scholar] [CrossRef]
- Druzhinina, I.S.; Seidl-Seiboth, V.; Herrera-Estrella, A.; Horwitz, B.A.; Kenerley, C.M.; Monte, E.; Mukherjee, P.K.; Zeilinger, S.; Grigoriev, I.V.; Kubicek, C.P. Trichoderma: The Genomics of Opportunistic Success. Nat. Rev. Microbiol. 2011, 9, 749–759. [Google Scholar] [CrossRef]
- Viterbo, A.; Montero, M.; Ramot, O.; Friesem, D.; Monte, E.; Llobell, A.; Chet, I. Expression Regulation of the Endochitinase Chit36 from Trichoderma asperellum (T. harzianum T-203). Curr. Genet. 2002, 42, 114–122. [Google Scholar] [CrossRef] [PubMed]
- Sharon, E.; Chet, I.; Viterbo, A.; Bar-Eyal, M.; Nagan, H.; Samuels, G.J.; Spiegel, Y. Parasitism of Trichoderma on Meloidogyne javanica and Role of the Gelatinous Matrix. Eur. J. Plant Pathol. 2007, 118, 247–258. [Google Scholar] [CrossRef]
- Atanasova, L.; Le Crom, S.; Gruber, S.; Coulpier, F.; Seidl-Seiboth, V.; Kubicek, C.P.; Druzhinina, I.S. Comparative Transcriptomics Reveals Different Strategies of Trichoderma Mycoparasitism. BMC Genom. 2013, 14, 121. [Google Scholar] [CrossRef] [PubMed]
- Thangavelu, R.; Varun, G.; Ganga Devi, P. Identification of Differentially Expressed Genes from Fusarium oxysporum f. sp cubense and Trichoderma asperellum (Prr2) Interaction in the Susceptible Banana Cultivar Grand Naine. Turk. J. Bot. 2016, 40, 480–487. [Google Scholar] [CrossRef]
- Anees, M.; Tronsmo, A.; Edel-Hermann, V.; Hjeljord, L.G.; Héraud, C.; Steinberg, C. Characterization of Field Isolates of Trichoderma Antagonistic against Rhizoctonia solani. Fungal Biol. 2010, 114, 691–701. [Google Scholar] [CrossRef]
- Anjum, N.; Shahid, A.A.; Iftikhar, S.; Mubeen, M.; Ahmad, M.H.; Jamil, Y.; Nasrullah Rehan, M.K.; Aziz, A.; Iqbal, S.; Abbas, A. Evaluations of Trichoderma Isolates for Biological Control of Fusarium Wilt of Chili. Plant Cell Biotechnol. Mol. Biol. 2020, 21, 42–57. [Google Scholar]
- Błaszczyk, L.; Basińska-Barczak, A.; Ćwiek-Kupczyńska, H.; Gromadzka, K.; Popiel, D.; Stępień, Ł. Supressive Effect of Trichoderma spp. on Toxigenic Fusarium Species. Pol. J. Microbiol. 2017, 66, 85–100. [Google Scholar] [CrossRef]
- Qualhato, T.F.; Lopes, F.A.C.; Steindorff, A.S.; Brandão, R.S.; Jesuino, R.S.A.; Ulhoa, C.J. Mycoparasitism Studies of Trichoderma Species against Three Phytopathogenic Fungi: Evaluation of Antagonism and Hydrolytic Enzyme Production. Biotechnol. Lett. 2013, 35, 1461–1468. [Google Scholar] [CrossRef]
- Fanelli, F.; Liuzzi, V.C.; Logrieco, A.F.; Altomare, C. Genomic Characterization of Trichoderma atrobrunneum (T. harzianum Species Complex) ITEM 908: Insight into the Genetic Endowment of a Multi-Target Biocontrol Strain. BMC Genom. 2018, 19, 662. [Google Scholar] [CrossRef]

| Percentage of Positive * Isolates in Each Species | |||||||||||||
|---|---|---|---|---|---|---|---|---|---|---|---|---|---|
| Glucanases | Chitinases | Proteases | |||||||||||
| Clade | Species | No. of Total Isolates | bgn13 | glyc | lam1.3 | egl1 | tv-ech1 | 42-kDa | chit36Y | p6281 | tvps1 | tri5 | No. of Positive Genes |
| Harzianum- Virens | T. aff. harzianum | 31 | 61.3 1 | 0 | 6.5 | 90.3 | 9.7 | 3.2 | 0 | 38.7 | 90.3 | 0 | 7 |
| T. harzianum | 10 | 80.0 | 0 | 20.0 | 60.0 | 70.0 | 20.0 | 0 | 20.0 | 80.0 | 0 | 7 | |
| T. afroharzianum | 2 | 50.0 | 0 | 0 | 100.0 | 50.0 | 0 | 0 | 0 | 100.0 | 0 | 4 | |
| T. guizhouense | 7 | 57.1 | 0 | 0 | 57.1 | 28.6 | 14.3 | 0 | 42.9 | 57.1 | 0 | 6 | |
| T. atrobrunneum | 11 | 100.0 | 0 | 0 | 63.6 | 36.4 | 0 | 0 | 54.5 | 100.0 | 54.5 | 6 | |
| T. hirsutum | 1 | 100.0 | 0 | 100.0 | 100.0 | 100.0 | 0 | 0 | 0 | 0 | 0 | 4 | |
| T. virens | 35 | 42.9 | 0 | 57.1 | 48.6 | 88.6 | 0 | 2.9 | 80.0 | 25.7 | 0 | 7 | |
| T. aff. hortense | 3 | 66.7 | 0 | 0 | 66.7 | 100.0 | 0 | 0 | 66.7 | 100.0 | 0 | 5 | |
| Trichoderma | T. hamatum | 4 | 0 | 100.0 | 75.0 | 0 | 0 | 75.0 | 75.0 | 0 | 0 | 0 | 4 |
| T. gamsii | 1 | 100.0 | 100.0 | 0 | 0 | 0 | 100.0 | 100.0 | 0 | 0 | 0 | 4 | |
| T. asperellum | 2 | 50.0 | 50.0 | 100.0 | 50.0 | 0 | 50.0 | 50.0 | 50.0 | 0 | 0 | 7 | |
| Longibrachiatum | T. longibrachiatum | 2 | 100.0 | 0 | 0 | 100.0 | 0 | 50.0 | 100.0 | 50.0 | 50.0 | 0 | 6 |
| All species | 109 | 59.6 2 | 5.5 | 27.5 | 64.2 | 47.7 | 9.2 | 7.3 | 50.5 | 60.6 | 5.5 | ||
| Percentage of positive species | 91.7 3 | 25.0 | 50.0 | 83.3 | 66.7 | 58.3 | 33.3 | 66.7 | 66.7 | 8.3 | |||
| Sample | Contigs | Longest Contigs | Total Reads 1 | Estimated Genome Size | %GC 2 | N50 3 |
|---|---|---|---|---|---|---|
| TF03 | 171 | 4.231.301 | 54.750.354 | 45.784.183 | 46.14 | 2.550.172 |
| Sample | #BGC | PKS 1 | NRPS 2 | Hybrid PKS-NRPS | Terpene Synthases |
|---|---|---|---|---|---|
| TF03 | 69 | 16 | 11 | 16 | 10 |
Disclaimer/Publisher’s Note: The statements, opinions and data contained in all publications are solely those of the individual author(s) and contributor(s) and not of MDPI and/or the editor(s). MDPI and/or the editor(s) disclaim responsibility for any injury to people or property resulting from any ideas, methods, instructions or products referred to in the content. |
© 2024 by the authors. Licensee MDPI, Basel, Switzerland. This article is an open access article distributed under the terms and conditions of the Creative Commons Attribution (CC BY) license (https://creativecommons.org/licenses/by/4.0/).
Share and Cite
Correa-Delgado, R.; Brito-López, P.; Cardoza, R.E.; Jaizme Vega, M.C.; Laich, F.; Gutiérrez, S. Biocontrol Potential of a Native Trichoderma Collection Against Fusarium oxysporum f. sp. cubense Subtropical Race 4. Agriculture 2024, 14, 2016. https://doi.org/10.3390/agriculture14112016
Correa-Delgado R, Brito-López P, Cardoza RE, Jaizme Vega MC, Laich F, Gutiérrez S. Biocontrol Potential of a Native Trichoderma Collection Against Fusarium oxysporum f. sp. cubense Subtropical Race 4. Agriculture. 2024; 14(11):2016. https://doi.org/10.3390/agriculture14112016
Chicago/Turabian StyleCorrea-Delgado, Raquel, Patricia Brito-López, Rosa E. Cardoza, María C. Jaizme Vega, Federico Laich, and Santiago Gutiérrez. 2024. "Biocontrol Potential of a Native Trichoderma Collection Against Fusarium oxysporum f. sp. cubense Subtropical Race 4" Agriculture 14, no. 11: 2016. https://doi.org/10.3390/agriculture14112016
APA StyleCorrea-Delgado, R., Brito-López, P., Cardoza, R. E., Jaizme Vega, M. C., Laich, F., & Gutiérrez, S. (2024). Biocontrol Potential of a Native Trichoderma Collection Against Fusarium oxysporum f. sp. cubense Subtropical Race 4. Agriculture, 14(11), 2016. https://doi.org/10.3390/agriculture14112016

